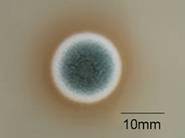

ページの本文です。
更新日付:2017年6月23日 / ページ番号:C015172
「保管していた食べ物にカビが生えてしまった。」ということはありませんか?
一言でカビと言っても、薬や食品などに使われ人の役に立つものから、強い毒性物質を産生するものまで様々な種類があります。
ここでは、実際に食品に生えたカビ、そしてそれらを培養した写真を用いて、どのようなカビが生えたのかをご説明します。




上の写真2枚は肉眼で観察できるカビの様子です。下2枚はカビの検査における写真です。
検査では、食べ物に生えているカビを取り、栄養素が入った寒天(培地)の上で育てます。次に、育てたカビを顕微鏡で観察し、全体の形を観察することで、どのようなカビなのか絞り込んでいきます。
生えていたカビはアスペルギルス属の一種でした。
アスペルギルス属は穀類、ナッツ類、香辛料などに生えます。また、室内環境においてアレルギーの原因となることがあります。
この属の中には、みそや清酒の醸造に必要なアスペルギルス・オリゼや、強い毒性をもつカビ毒アフラトキシンを産生することがあるアスペルギルス・フラバスなどがいます。
アスペルギルス属の詳細については「食品に生えるカビについて」をご覧ください。




生えていたカビはペニシリウム属の一種でした。
ペニシリウム属は生鮮果実・野菜、穀類、加工食品などに生えます。種類によりカビ毒を産生するものもいます。
この属の一種のペニシリウム・ジギタータムは、ミカンなどのかんきつ類の腐敗の原因となります。
ペニシリウム属の詳細については「食品に生えるカビについて」をご覧ください。

生えていたカビはクラドスポリウム属(上段)とペニシリウム属(下段)の二種類でした。
クラドスポリウム属は空気中に浮遊するカビの中で最も多いとされており、乾燥穀類、貯蔵食品などから検出されることがあります。
カビ毒は産生しないと言われていますが、アレルギーの原因となることが知られています。
クラドスポリウム属の詳細については「食品に生えるカビについて」をご覧ください。
全てのカビが強い毒を産生するわけではありません。しかし、一見しただけではどのような種類のカビなのか判断することは困難です。また、カビの生えた食品は、カビを取り除いたとしても目に見えない部分に入り込んでいる可能性があります。カビの生えた食品は極力食べないようにしましょう。
保健衛生局/健康科学研究センター/生活科学課
電話番号:048-840-2260 ファックス:048-840-2267